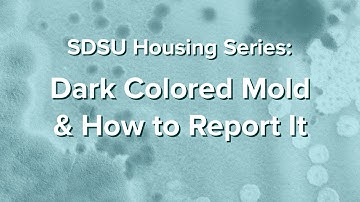
Dark Colored Mold and How to Report It - SDSU Housing Series: Part 3

⬇ DOWNLOAD NOW
Kalau muncul iklan pop-up, tutup lalu klik tombol kembali
Download lagu What is Mold and How to Prevent It - SDSU Housing Series: Part 1 secara gratis hanya untuk keperluan promosi. Dukung artis favorit kamu dengan membeli musik original di iTunes atau platform resmi lainnya.
Dark Colored Mold and How to Report It - SDSU Housing Series: Part 3
Dark Colored Mold and How to Report It - SDSU Housing Series: Part 3
 How Temperature and Food Sources Impact Mold - SDSU Housing Series: Part 2
How Temperature and Food Sources Impact Mold - SDSU Housing Series: Part 2
 SDSU Housing Office - Residential Education Values
SDSU Housing Office - Residential Education Values
 Mold Found In SDSU Meadows Apartments
Mold Found In SDSU Meadows Apartments
 Rape reported at SDSU apartment
Rape reported at SDSU apartment
 SDSU, IVC student housing project expected to be completed by 2026
SDSU, IVC student housing project expected to be completed by 2026
 SDSU Housing
SDSU Housing
 3 Things Mold MUST Have to Grow (Build Safe!)
3 Things Mold MUST Have to Grow (Build Safe!)